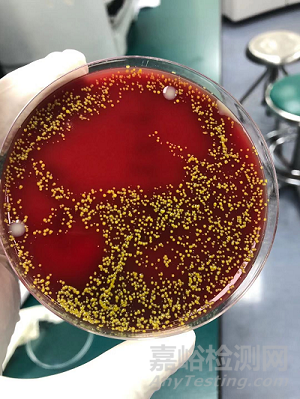

水是實驗室常用的試劑之一,那檢驗科對于實驗室用水有什么規(guī)定�����?電阻率是大于1還是大于10MΩ·cm(25℃)����?多久做一次細(xì)菌培養(yǎng)����?細(xì)菌計數(shù)要求是什么呢����?配制試劑和校準(zhǔn)液“0濃度”又是用的什么水呢�����?是滅菌注射用水還是水機(jī)純化水��?
接下來就跟大家分享一個我們在日常工作中和實驗室用水相關(guān)的案例��。
案例經(jīng)過
2021年2月3日��,由于科室AST項目校準(zhǔn)周期到期����,需對其重新進(jìn)行校準(zhǔn)并做質(zhì)控,低水平質(zhì)控在控�����,高水平質(zhì)控高于1 2S,因并未失控所以未做任何處理����。
2021年2月4日,質(zhì)控發(fā)現(xiàn)AST 2 2S失控����,排除其他因素并更換試劑,重新校準(zhǔn)后再次做質(zhì)控��,仍失控����,最后更換“0濃度用水”重新校準(zhǔn),結(jié)果在控�����。
因而得出結(jié)論:校準(zhǔn)所用“0濃度用水”的水質(zhì)被污染����。
案例分析
質(zhì)控結(jié)果如圖1所示,低水平質(zhì)控在控����,高水平高于1 2S��,因并未失控未做任何處理�����。
圖1 第一次質(zhì)控結(jié)果
2021年2月4日�����,再一次進(jìn)行質(zhì)控發(fā)現(xiàn)AST 2 2S失控,結(jié)果如圖2所示��。
圖2 第二次質(zhì)控結(jié)果
崗位人員進(jìn)行原因排查:
1. 崗位人員無變化����,且均按照正常操作流程進(jìn)行質(zhì)控操作,排除人員問題�����;
2. 查看質(zhì)控靶值及SD的設(shè)置�����,確認(rèn)均無問題��;
3. 查看本質(zhì)控其余項目,顯示結(jié)果良好����,排除儀器及質(zhì)控品問題;
4. 懷疑校準(zhǔn)品問題����,重新溶解校準(zhǔn)品,重新校準(zhǔn)��,結(jié)果仍失控(結(jié)果如圖3所示)��。
圖3 第三次質(zhì)控結(jié)果
考慮是否為試劑本身問題�����,進(jìn)行更換試劑����,重新校準(zhǔn)后做質(zhì)控,仍失控(結(jié)果如圖4所示)����。
圖4 第四次質(zhì)控結(jié)果
排除了人員、儀器、試劑等因素����,此時還有一個實驗室容易忽略的影響因素:實驗室用水。我們實驗室用的是瓶裝滅菌注射用水��,當(dāng)時使用的水已經(jīng)開瓶5天����,是不是水受到污染了?重新使用全新未開封的瓶裝滅菌注射用水�����,校準(zhǔn)后����,質(zhì)控在控�����。
圖5 第五次質(zhì)控結(jié)果
校準(zhǔn)所用“0濃度用水”出現(xiàn)了問題����,我們分析可能是由以下兩個原因造成,第一種可能是存在物質(zhì)干擾或電導(dǎo)率影響;第二種可能是存在細(xì)菌生長�����。
針對這兩個方面�����,我們做了以下實驗����。首先分別檢測新舊滅菌注射用水及水箱水中的鉀鈉氯鈣鎂磷TCO2及AST,發(fā)現(xiàn)三者各個項目并無差異��。說明物質(zhì)干擾或電導(dǎo)率影響的可能性較小����。
各項指標(biāo)均無差異,會不會是水質(zhì)受到污染����?我們對其加做微生物培養(yǎng),如圖6所示����,“0濃度用水”受到微生物污染導(dǎo)致結(jié)果異常。細(xì)究原因,部分人員取水時習(xí)慣使用加樣槍吸取使用����,而加樣槍吸頭長期暴露于空氣中,久之滋生細(xì)菌進(jìn)而導(dǎo)致用水污染����,干擾實驗結(jié)果。
圖6 校準(zhǔn)液“0濃度用水”血平板培養(yǎng)結(jié)果
那么實驗室用水對于細(xì)菌計數(shù)有什么要求呢��?工作人員查了相關(guān)資料��,在行標(biāo)文件WS/T 574—2018《臨床實驗室試劑用純化水》(見圖7)中查到�����,用于臨床實驗室一般實驗的試劑配制�����、校準(zhǔn)品和質(zhì)控品復(fù)溶等用途的純水�����,微生物總數(shù)應(yīng)<10 CFU/mL ����,很明顯,之前的舊水遠(yuǎn)遠(yuǎn)超過了這個范圍�����。
工作人員又發(fā)現(xiàn)一個問題����,文件要求實驗室用水電阻率應(yīng)≥10 MΩ·cm(25℃),或者電導(dǎo)率≤0.1μS/cm(25℃)����,那么瓶裝滅菌注射用水達(dá)到這個要求了嗎?查閱相關(guān)資料����,這種水的要求是電導(dǎo)率<1.3μS/cm(25℃),遠(yuǎn)達(dá)不到0.1μS/cm(25℃)的標(biāo)準(zhǔn)?���,F(xiàn)科室水機(jī)儀器本身有檢測電阻率功能,且滿足電阻率要求����,同時實驗室也規(guī)定水機(jī)純化水電阻率應(yīng)≥10 MΩ·cm����,若低于此值����,應(yīng)當(dāng)聯(lián)系水機(jī)工程師更換耗材。
結(jié)合以上信息��,我們將校準(zhǔn)液“0濃度用水”改為使用水機(jī)純化水�����。但是使用水機(jī)純化水也有很多事項需要大家注意�����,要注意每天登記電導(dǎo)率或電阻率數(shù)值��,有問題及時聯(lián)系水機(jī)工程師����;及時更換耗材����,包括活性炭��,保安過濾器�����,RO 膜�����,樹脂����,濾芯等等����;每月一次細(xì)菌培養(yǎng),包括水機(jī)出水端和儀器進(jìn)水端��,以免有細(xì)菌滋生����;定期清潔水箱及管道,尤其是外接管道����。


圖7 WS/T 574-2018 臨床實驗室試劑用純化水
實驗室用水要點(diǎn)
失控分析考慮全����,校準(zhǔn)用水是關(guān)鍵����;
實驗用水用途廣,影響結(jié)果不容覷����。
電導(dǎo)電阻合要求,細(xì)菌計數(shù)少不了�����;
水箱管道勤清潔��,耗材更換要做好��。